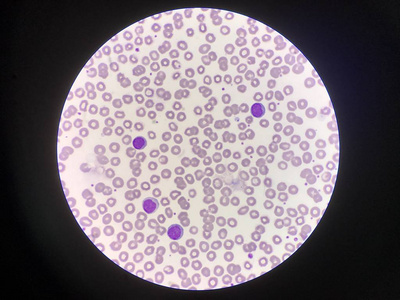
造血系统红细胞背景成熟淋巴细胞.照片

红细胞 成熟

成熟红细胞有dna和rna吗?
图片尺寸500x300
混合血液混合的成熟的白色的血细胞向红色的血细胞背景照片
图片尺寸304x300
造血系统红细胞背景成熟淋巴细胞.照片
图片尺寸400x300
正常红细胞(图片来源网络)
图片尺寸600x600
医学科普原来你是这样的红细胞
图片尺寸758x375
成熟红细胞
图片尺寸554x246
血红细胞医学背景照片
图片尺寸389x300
为什么哺乳动物的成熟「红细胞」一般没有细胞核? - 知乎
图片尺寸960x720
红细胞,红血细胞,解剖医学概念
图片尺寸700x394
红细胞可成药物新载体
图片尺寸600x600
在血管中的血红细胞
图片尺寸700x369
人的成熟的红细胞
图片尺寸1080x810
图为正常红细胞
图片尺寸1000x750
【2049日报】s04e109 哺乳动物红细胞为何没有细胞核
图片尺寸1200x750
医学 儿科学 课件 讲义 , 缺铁性贫血红细胞形态:图示成熟红细胞 大小
图片尺寸1080x810
红细胞计数(2015)ppt
图片尺寸1170x810
红血细胞显微镜在医学背景概念下
图片尺寸700x688
嗜碱性粒细胞增加;nrbc present:有核红细胞增加;ig present:未成熟粒
图片尺寸847x848
血细胞可分为红细胞,白细胞和血小板.
图片尺寸5760x3162
显微镜下红细胞红细胞特写的三维图.科学医学概念的背景.
图片尺寸700x467